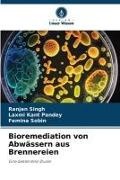

En savoir plus
Die Abfallbewirtschaftung ist ein globales Problem, mit dem sich der gesamte Globus derzeit auseinandersetzt. Die Zusammensetzung und die Eigenschaften der Schadstoffe in den Abwässern sind unbekannt, was die größte Sorge darstellt. Bei der Bioremediation wird die hohe und vielseitige Stoffwechselaktivität von Mikroorganismen genutzt, um Schadstoffe in Industrieabwässern, insbesondere in Brennereiabwässern, abzubauen. Ihre leichte Verfügbarkeit und ihr erschwinglicher Preis machen sie zur bevorzugten Option. Bei der Bioremediation werden Bakterien mit starker Stoffwechselaktivität eingesetzt, um Schadstoffe in Industrieabwässern, insbesondere in Abwässern von Brennereien, abzubauen. Mikroorganismen, allein oder in Verbindung mit anderen Mikroorganismen, schaffen ein Umfeld, das nicht nur den Abbau von Schadstoffen, sondern auch die Produktion einiger nützlicher Nebenprodukte begünstigt. Diese Arbeit konzentriert sich auf die Bioremediation von Brennereiabwässern mit Hilfe von Bakterienstämmen. Das Buch ist für Studenten, Forscher, Lehrer und alle am Thema interessierten Personen von Interesse.
A propos de l'auteur
O Dr. Ranjan Singh trabalha atualmente como Professor Assistente no Departamento de Botânica e Microbiologia, St. Aloysius College, Jabalpur, M.P., Índia. A sua área de interesse é a microbiologia aplicada. Tem 4 anos de experiência de ensino, 1,5 anos de experiência industrial e 6 anos de experiência de investigação. Publicou mais de 12 artigos e 6 livros.